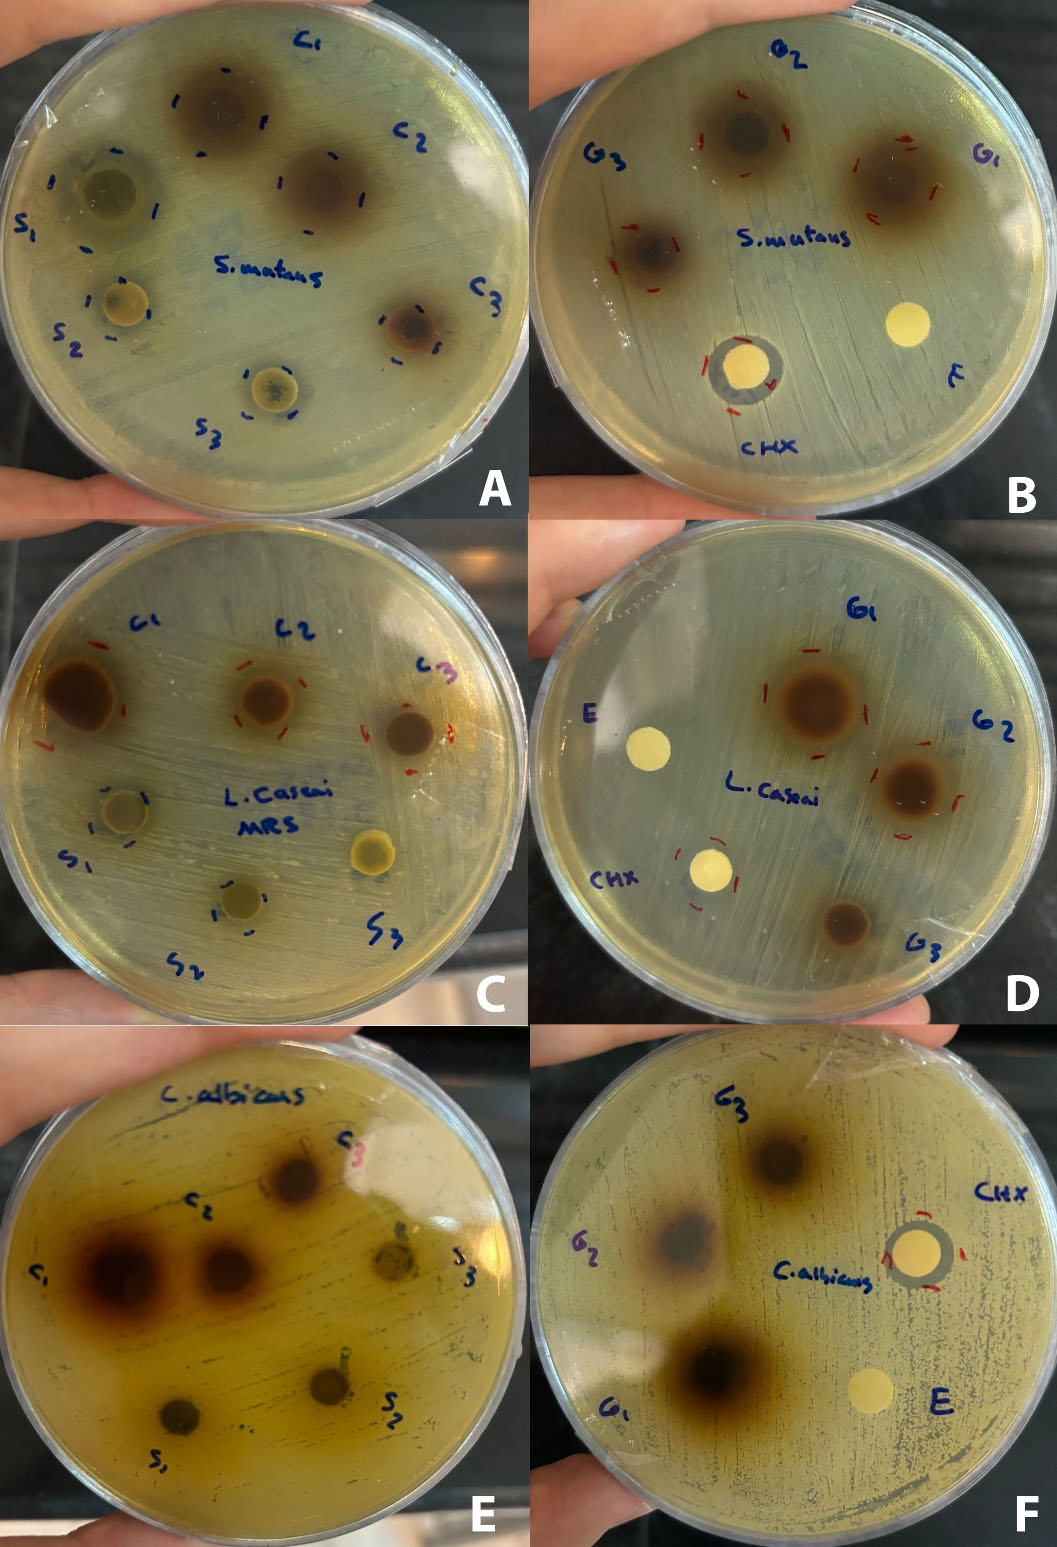
japid-17-46-g003
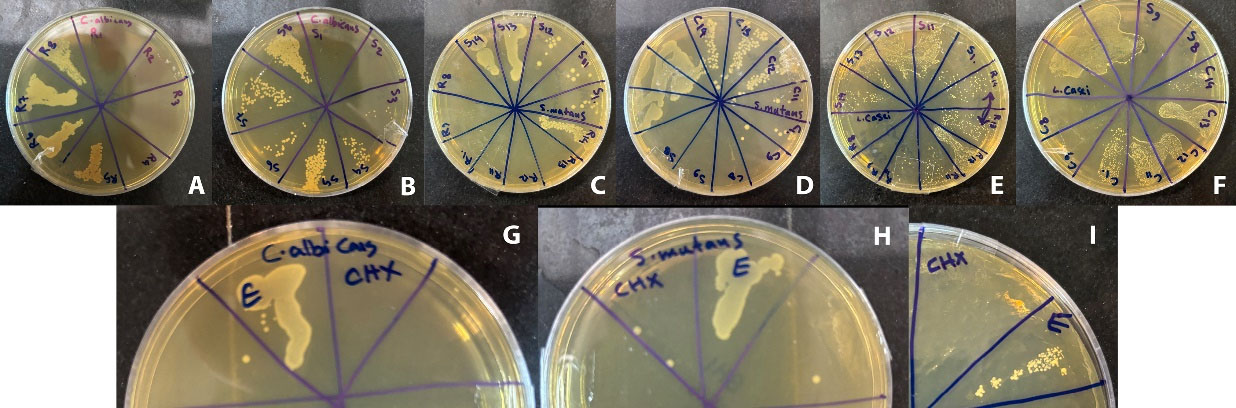
japid-17-46-g004

J Adv Periodontol Implant Dent. 17(1):46-53.
doi: 10.34172/japid.025.3710
Original Article
Antimicrobial efficacy and cytotoxicity of ethanolic extracts of Salvia officinalis and Juglans regia against oral pathogens
Sara Ghadaksaz Conceptualization, Data curation, Funding acquisition, Investigation, Project administration, Visualization, Writing – original draft, Writing – review & editing, 1 
Safar Farajnia Conceptualization, Funding acquisition, Methodology, Project administration, Supervision, Validation, Visualization, Writing – review & editing, 2, * 
Fatemeh Pournaghiazar Conceptualization, Formal analysis, Funding acquisition, Methodology, Project administration, Supervision, Validation, Visualization, Writing – review & editing, 3, * 
Hamed Ebrahimzadeh Leylabadlo Methodology, Validation, Writing – review & editing, 4 
Reza Salahlou Data curation, Investigation, Writing – review & editing, 5 
Abbas Delazar Methodology, Supervision, Validation, Writing – review & editing, 5 
Amir Zandesh Data curation, Investigation, Writing – original draft, Writing – review & editing, 1 
Author information:
1Dental and Periodontal Research Center,Tabriz University of Medical Sciences, Tabriz, Iran
2Biotechnology Research Center, Tabriz University of Medical Sciences, Tabriz, Iran
3Department of Operative Dentistry, Faculty of Dentistry, Tabriz University of Medical Sciences, Tabriz, Iran
4Liver and Gastrointestinal Diseases Research Center, Tabriz University of Medical Sciences, Tabriz, Iran
5Drug Applied Research Center, Tabriz University of Medical Sciences, Tabriz, Iran
Abstract
Background.
Herbal extracts have gained attention for their potential benefits in promoting oral health and preventing dental caries and periodontal diseases. This study evaluated the antimicrobial effects and cytotoxicity of ethanolic extracts of Salvia officinalis and Juglans regia, both individually and in combination, against Streptococcus mutans, Lactobacillus casei, and Candida albicans, microorganisms associated with oral diseases.
Methods.
In this in vitro study, the hydroalcoholic (ethanolic) extracts of J. regia and S. officinalis were prepared using the maceration method. To determine the antimicrobial effectiveness, the zone of inhibition in the disk agar diffusion, minimum inhibitory concentration (MIC) and minimum bactericidal concentration (MBC) were assessed for each extract, separately and in combination. The extracts’ cytotoxicity was investigated at their effective doses using the MTT (methyl thiazole tetrazolium) assay.
Results.
Compared to the negative control, ethanolic extracts of S. officinalis and J. regia exhibited a significant inhibitory effect (P<0.001) on S. mutans and L. casei. Salvia officinalis extract exhibited antimicrobial activities, as evidenced by the MIC values of 237.5 µg/mL for S. mutans, 118.7 µg/mL for Lactobacillus casei, and 31.25 mg/mL for C. albicans. The ethanolic extract of Juglans regia exhibited MIC values of 29.6 µg/mL for S. mutans, 475 µg/mL for L. casei, and 15.62 mg/mL for C. albicans, respectively. MTT assay results showed that the extracts had no cytotoxic effects at the MIC on the L929 cell line; however, pure chlorhexidine was toxic at 0.2% concentration.
Conclusion.
The study results revealed that the ethanolic extracts of S. officinalis and J. regia and their combined application showed antimicrobial activity against pathogenic microorganisms pertinent to oral health. In addition, cytotoxicity evaluations indicated that these extracts are non-toxic to the L929 cell line at effective concentrations.
Keywords: Candida albicans, Dental caries, Dentistry, Lactobacillus casei, Oral hygiene, Periodontal diseases, Streptococcus mutans
Copyright and License Information
© 2025 The Author(s).
This is an open access article distributed under the terms of the Creative Commons Attribution License (
http://creativecommons.org/licenses/by/4.0/), which permits unrestricted use, distribution, and reproduction in any medium, provided the original work is properly cited.
Funding Statement
The Vice Chancellor for Research at Tabriz University of Medical
Sciences provided financial support for this research study (grant number: 71614).
Introduction
The oral microbiome, characterized by its dynamic and polymicrobial nature, is a fundamental precursor to periodontitis (PD) and dental caries, ranking high among the most common microbially induced diseases globally. As these microbial communities evolve, the metabolic activities of the microorganisms, coupled with the by-products generated by the host immune response, induce alterations in the local environment. These environmental changes promote the proliferation or increased representation of specific microorganisms associated with a dysbiotic state, contributing to the pathogenesis of oral diseases.1,2 PD is a long-lasting inflammatory state that damages the periodontal ligaments surrounding the teeth. Standard nonsurgical procedures, such as scaling and root planing (SRP), often need additional therapies to improve effectiveness, as they do not always completely eliminate pathogens.3 Dental caries (tooth decay) occurs through a natural mechanism in which bacteria in the oral biofilm cause oscillations in pH, leading to enamel demineralization and the formation of apparent lesions.4 Caries, if left untreated, can cause pain and abscess and may even lead to systemic infections, as well as functional or psychosocial impairment.5 The correlation between PD and dental caries has been a topic of debate in recent years. Some studies have indicated an inverse relationship, while others have found a positive correlation between these two diseases.6,7 Also, a recent systematic review demonstrated that the two disorders are interconnected through bidirectional relationships. This finding underscores the complexity of their interaction so managing the pathological microbial environment in the oral cavity is essential for controlling both periodontal diseases and dental caries, as it helps to prevent the progression and exacerbation of these common oral diseases.8
Controlling dental biofilm is achieved through various methods, including using mouth rinses containing chlorhexidine gluconate (CHX) as a major ingredient. CHX is utilized for its potential effectiveness in managing oral soft tissue diseases, PD, plaque-induced gingivitis, and dental caries. Additionally, repeated use of this compound may result in side effects such as tooth discolorations, loss of taste perception, and the potential development of antimicrobial resistance (AMR).9,10 However, natural products have demonstrated biological compatibility and possess therapeutic benefits.11 For that reason, the development of alternative biologically active antimicrobial natural agents capable of acting synergistically against oral microbial biofilm, which causes dental carious process and periodontal diseases, is essential.12 That is why plant-derived extracts or bioactive substances are considered a desirable alternative to routine antibiotics and synthetic agents with less side effects and also, to overcome the crisis of AMR.13
Juglans regia, commonly known as Iranian walnut, belongs to the Juglandaceae family and is widely found worldwide. Different parts of the plant have significant therapeutic uses.14 The leaves are easily available in large quantities and serves as a source of health care compounds. They are used in indigenous medicine to treat hypoglycemia, diarrhea, chronic venous insufficiency, hemorrhoids, and microbial or fungal infections.15J. regia stem is used as an anti-diarrhea and anti-parasitic agent, and the dried trunk bark is traditionally used as a toothbrush in some countries.16 Some in vitro studies have demonstrated the biological properties of J. regia extract, including anti-proliferative, anti-inflammatory properties, and broad-spectrum antimicrobial activity; it prevents the growth of several types of pathogenic microorganisms.17-19
Salvia officinalis L. (Sage) is an aromatic perennial shrub of the Labiatae/ Lamiaceae family. Sage is the largest species of this family. The plants of this family are found all around the world, and the S. officinalis species is indigenous to the Mediterranean and Middle East regions. It has become natural worldwide, especially in North America and Europe.20,21 Recent studies have been executed to document the traditional applications and investigate new biological properties of different parts of this plant. These research studies have shown an extensive range of medicinal activities, including anti-cancer, anti-inflammatory, analgesic, anti-mutagenic, antioxidant, antimicrobial, anti-dementia, glucose lowering, and blood lipid-lowering effects. Ethanolic extract and essential oil of S. officinalis have strong antibacterial and bacteriostatic effects against gram-negative and gram-positive pathogens. Among gram-positive bacteria, Bacillus cereus, Bacillus subtilis, Bacillus megaterium, Staphylococcus epidermidis, Enterococcus faecalis, and Listeria monocytogenes show high susceptibility to this extract. The effects of S. officinalis on gram-negative bacteria depend on the type of extraction method used, and S. officinalis essential oil has a considerable inhibitory effect on the growth of Escherichia coli, Klebsiella pneumoniae, Klebsiella oxytoca, Pseudomonas morgana, Aeromonas sobria, Aeromonas hydrophila, Salmonella anatoma, Salmonella typhi, Salmonella enteritidis, and Shigella sonnei. This plant’s broad antibacterial and antifungal effect on a wide range of microorganisms such as Pseudomonas, Aspergillus, and Candida has been reported.22-24
The current study aimed to determine the antimicrobial properties of J. regia and S. officinalis ethanolic extracts and their combination on oral pathogenic species, namely Streptococcus mutans, Lactobacillus casei, and Candida albicans, compared to 0.2% chlorhexidine (Behsa, Iran). Additionally, the cytotoxicity of substances was evaluated using the MTT assay. Considering this information, J. regia bark and S. officinalis aerial parts may have the potential for application in oral healthcare products.
Methods
This in vitro study was conducted at the Biotechnology Research Center, Tabriz University of Medical Sciences, from October 2023 to August 2024. The Ethics Committee of the Research and Technology Vice-Chancellor of Tabriz University of Medical Sciences approval code is IR.TBZMED.VCR.REC.1402.117.
Preparation of extracts
Bark of J. regia and the aerial parts of S. officinalis were purchased from local markets in Tabriz (Iran) and identified by a pharmacologist. Extraction was performed by maceration technique by soaking 200 g of fine powder in 2000 mL of ethanol for each plant species. After covering the heads of the Erlenmeyer flask with aluminum foil, it was placed on a shaker at 90 rpm for 48 hours (Heidolph Unimax, Germany). After the solvent and the plant were homogenized, the solutions were filtered by 0.5-mm Watman filter paper (Watman, USA) and placed in a rotary evaporator (Heidolph WD 2000, Germany) to separate the solvent from the extract. The obtained pure extract was stored in the refrigerator (-18 ºC) in sterile vials for the microbial and cytotoxicity tests.
Preparation of microbial species
Streptococcus mutans (PTCC: 1683), L. casei (PTCC: 1608),and C. albicans (PTCC: 5027) standard microbial strains were prepared in lyophilized form from the Persian Type Culture Collection (PTCC, Tehran, Iran) reference center. To prepare bacteria from lyophilized samples, first, the samples were cultured in a liquid broth culture medium overnight at 35 ºC. After creating turbidity in the liquid broth culture medium, to ensure purity, the samples were isolated on the solid culture medium [BHI agar (Spain, CONDA) for C. albicans and S. mutans andMRS agar (Germany, Merck) for L. casei].
Determination of antimicrobial effects using the agar disk diffusion method
Antimicrobial activity was assessed using the agar disk diffusion method explained by Finegold and Mart, 1982.22 Each extract was prepared in three concentrations of 1000, 500, and 250 mg/mL. Then, blank paper disks (6.4-mm blank paper disks) were loaded with 30 µL. Also, discs impregnated with chlorhexidine (positive control) and ethanol (negative control) were prepared as control groups. The specific culture medium of different strains of microorganisms was cultivated using a sterile cotton swab with suspensions containing 0.5 McFarland, and discs containing the extract were placed on all prepared plates and kept at 37 ºC for 24 hours. The diameter of the inhibited areas was measured and recorded as the average diameter of complete growth inhibition.25-27
Determining the minimum inhibitory concentration
To measure the minimum inhibitory concentration (MIC) for each of J. regia and S. officinalis extracts and their combination, 14 different concentrations in the range of 250 mg/mL to 29.6 µg/mL were prepared using broth medium according to the broth microdilution method (CLSI M07 protocol). An 0.5 McFarland (1.5 × 108 CFU/mL) suspension was prepared for each microbial species in the test tube. Then, the MIC was investigated in a 96-well microplate. Chlorhexidine was used as a positive control, and ethanol was used as a negative control. After incubation, the growth or non-growth of microorganisms was evaluated by checking the turbidity in the wells. The concentration of the first well in which no growth was observed was the MIC of the microorganism growth by that extract.
Determining the minimum bactericidal concentration
The contents of the microplate wells in which the MIC determination test was performed (after recording the results) were transferred to the surface of the nutrient agar culture medium by a sampler comprising 10 µL and cultivated. Then, the plates were incubated at 37ºC for 24 hours. After this period of incubation time, the minimum concentration of the well that led to the inhibition of bacterial growth on the surface of the nutrient agar plate was assessed as the minimum bactericidal concentration (MBC).28,29
Evaluation of cytotoxicity
The MTT assay (methylthiazol tetrazolium) method was used to investigate the cytotoxic effects of the samples. In 96‐well cell culture plates, the L929 fibroblasts were exposed to different concentrations of J. regia and S. officinalis (1/2 MIC, 1 MIC, and 2 MIC) and chlorhexidine mouthwash (1, 10, and 100%) for 1 min and 5 min, at 37 ºC. Finally, the absorbance of the plates was read at 570 nm through an ELISA plate reader.
Statistical analysis
The results were reported as descriptive statistics (Mean ± SD). One-way analysis of variance (ANOVA) was used to compare the groups. SPSS software (version 25, USA) was used for data analysis. The significance level was defined at < 0.05.
Results
Disk diffusion
Tables 1 and 2 present the inhibition zones due to S. officinalis and J. regiaethanolic extracts and their combination in three concentrations (1000, 500, and 250 mg/mL), negative control (70% ethanol) and positive control (0.2% chlorhexidine).
Table 1.
The results of the disk diffusion method for Lactobacillus casei
|
Organism
|
Sample
|
Diameter of inhibition zone (mm)
|
P
value
|
|
Lactobacillus casei
|
Salvia officinalis 1000 mg/mL |
9.13 ± 0.40 |
< 0.001 |
| Salvia officinalis 500 mg/mL |
8.16 ± 0.35 |
| Juglans regia 1000 mg/mL |
13.03 ± 0.30 |
| Juglans regia 500 mg/mL |
10.93 ± 0.25 |
| Juglans regia 250 mg/mL |
7.96 ± 0.32 |
| Combination 1000 mg/mL |
13.96 ± 0.35 |
| Combination 500 mg/mL |
12.03 ± 0.30 |
| Combination 250 mg/mL |
11.00 ± 0.36 |
| Chlorhexidine |
11.23 ± .057 |
Table 2.
The results of the disk diffusion method for Streptococcus mutans
|
Organism
|
Samples
|
Diameter of Inhibition Zone (mm)
|
P
value
|
|
Streptococcus mutans
|
Salvia officinalis 1000 mg/mL |
15.80 ± 0.36 |
< 0.001 |
|
Salvia officinalis 500 mg/mL |
12.16 ± 0.05 |
|
Salvia officinalis 250 mg/mL |
8.93 ± 0.15 |
|
Juglans regia 1000 mg/mL |
12.06 ± 0.15 |
|
Juglans regia 500 mg/mL |
11.06 ± 0.32 |
|
Juglans regia 250 mg/mL |
10.10 ± 0.45 |
| Combination 1000 mg/mL |
13.00 ± 0.17 |
| Combination 500 mg/mL |
10.96 ± 0.32 |
| Chlorhexidine |
12.10 ± 0.26 |
According to the results, S. officinalis exhibited a significant inhibitory effect (P < 0.001) on Streptococcus mutans and L. casei species compared to the negative control. Also, the inhibition zone of Salvia officinalis (1000 mg/mL) against S. mutans was significantly (P < 0.0001) larger than the inhibition zone of chlorhexidine (0.2%). Juglans regiaexerted a significant inhibitory effect (P < 0.001) on S. mutans and L. casei species compared to the negative control. However, none of the extracts and their combination showed an inhibitory zone against C. albicans (Figures 1to 3).

Figure 1.
The Results of the Disk Diffusion Method for Lactobacillus casei. Column charts and error bars represent means ± SD
.
The Results of the Disk Diffusion Method for Lactobacillus casei. Column charts and error bars represent means ± SD

Figure 2.
The Results of the Disk Diffusion Method for Streptococcus mutans. Column charts and error bars represent means ± SD
.
The Results of the Disk Diffusion Method for Streptococcus mutans. Column charts and error bars represent means ± SD
Figure 3.
The Results of the Disk Diffusion Method for Extracts. Zones of inhibition of Streptococcus mutans (A and B), Lactobacillus casei (C and D), and Candida albicans (E and F). “R” stands for Juglans regia extract, “S” stands for Salvia officinalis extract, “C” stands for the combination of Juglans regia and Salvia officinalis extract, “E” stands for 70% ethanol, “CHX” stands for chlorhexidine. Different concentrations of extractsin mg/mL: 1:1000, 2:500, 3:250
.
The Results of the Disk Diffusion Method for Extracts. Zones of inhibition of Streptococcus mutans (A and B), Lactobacillus casei (C and D), and Candida albicans (E and F). “R” stands for Juglans regia extract, “S” stands for Salvia officinalis extract, “C” stands for the combination of Juglans regia and Salvia officinalis extract, “E” stands for 70% ethanol, “CHX” stands for chlorhexidine. Different concentrations of extractsin mg/mL: 1:1000, 2:500, 3:250
MIC and MBC tests
MIC and MBC results showed that Juglans regia bark ethanolic extract exerted the strongest inhibitory and bactericidal effects on S. mutans with an MIC of 29.6 µg/mL. The ethanolic extract of S. officinalis had the lowest MIC (118.7 µg/mL) on L. casei. In addition, C. albicans showed less sensitivity to the extracts. However, no synergistic effect was observed in a combination of the two extracts (Figure 4). The MIC and MBC were evaluated for antimicrobial activity, and the results are summarized in Tables 3 and 4.
Figure 4.
The Results of the MBC forExtracts. MBC results of Candida albicans (A, B, and G), Streptococcus mutans (C, D, and H), and Lactobacillus casei (E, F, and I). “R” stands for Juglans regia extract, “S” stands for Salvia officinalis extract, “C” stands for the combination of Juglans regia and Salvia officinalis extract, “E” stands for ethanol, “CHX” stands for chlorhexidine. Different concentrations of extractsin μg/mL: 1: 250 × 103, 2: 125 × 103, 3: 62.5 × 103, 4: 31.25 × 103, 5: 15.62 × 103, 6: 7.81 × 103, 7: 3.9 × 103, 8: 1.9 × 103, 9:0.95 × 103, 10: 475, 11: 237.5, 12: 118.7, 13: 59.3, 14: 29.6
.
The Results of the MBC forExtracts. MBC results of Candida albicans (A, B, and G), Streptococcus mutans (C, D, and H), and Lactobacillus casei (E, F, and I). “R” stands for Juglans regia extract, “S” stands for Salvia officinalis extract, “C” stands for the combination of Juglans regia and Salvia officinalis extract, “E” stands for ethanol, “CHX” stands for chlorhexidine. Different concentrations of extractsin μg/mL: 1: 250 × 103, 2: 125 × 103, 3: 62.5 × 103, 4: 31.25 × 103, 5: 15.62 × 103, 6: 7.81 × 103, 7: 3.9 × 103, 8: 1.9 × 103, 9:0.95 × 103, 10: 475, 11: 237.5, 12: 118.7, 13: 59.3, 14: 29.6
Table 3.
MIC results for the samples against the selected organisms
|
Extracts
|
Streptococcus mutans
|
Lactobacillus casei
|
Candida albicans
|
|
Salvia officinalis
|
237.5 µg/mL |
118.7 µg/mL |
31.25 × 103 µg/mL |
|
Juglans regia
|
29.6 µg/mL |
475 µg/mL |
15.62 × 103 µg/mL |
| Combination |
118.7 µg/mL |
237.5 µg/mL |
15.62 × 103 µg/mL |
| Ethanol |
+ |
+ |
+ |
| chlorhexidine |
- |
- |
- |
| Broth + microorganism |
+ |
+ |
+ |
| Extract + broth |
- |
Table 4.
MBC results for the samples against the selected organisms
|
Extracts
|
Streptococcus mutans
|
Lactobacillus casei
|
Candida albicans
|
|
Salvia officinalis
|
0.95 × 103 µg/mL |
475 µg/mL |
62.5 × 103 µg/mL |
|
Juglans regia
|
29.6 µg/mL |
0.95 × 103 µg/mL |
31.25 × 103 µg/mL |
| Combination |
237 µg/mL |
0.95 × 103 µg/mL |
31.25 × 103 µg/mL |
| Ethanol |
+ |
+ |
+ |
| chlorhexidine |
- |
- |
- |
| Broth + microorganism |
+ |
+ |
+ |
| Extract + broth |
- |
Cytotoxicity test
Based on the cytotoxicity test results on the L929 cell line, the extracts and their combination had no toxic effect in their MIC concentration on S. mutans compared to the positive control. However, chlorhexidine (0.2%) in pure commercial concentration and diluted to 10% showed cytotoxic effects, but the diluted concentration of 1% chlorhexidine had no toxicity compared to the positive control.
Discussion
In the present study, disk diffusion results showed that the ethanolic extract of S. officinalis exhibited a significant inhibitory effect on bacterial species S. mutans and L. casei compared to the negative control, the inhibition zone of S. officinalis (1000 mg/mL) against S. mutans was significantly larger than chlorhexidine. The S. officinalis MIC values for S. mutans and L. casei were 237.5 and 118.7 µg/mL, respectively. The J. regia MIC values for S. mutans and L. casei were 29.6 and 475 µg/mL, respectively. The S. officinalis and J. regia MIC values for Candida albicans were 31.25 and 15.62 mg/mL, which indicates the lower sensitivity of C. albicans compared to the other two studied species.
According to Kermanshah et al,30 S. officinalis has a growth inhibitory effect against S. mutans, Actinomyces viscose, and Lactobacillus rhamnosus. The MIC and MBC of hydroalcoholic extract of S. officinalis on S. mutans were 6.25 and 50 µg/mL, respectively. Comparison between the results indicates that, despite similar test conditions in the above study and ours, Kermanshah et al observed stronger antimicrobial effects of the S. officinalis hydroalcoholic extract. This discrepancy may be attributed to variations in the concentration of the plant’s active compounds, likely resulting from growth under different environmental conditions.
Sookto et al31 investigated the anticandidal activities of S. officinalis against C. albicans. S. officinalis extract showed anticandidal activity against the C. albicans strain with an inhibition zone of 19.5‒40.5 mm.
A previous study highlighted a notable improvement in bleeding on probing parameter (BOP) within the test group that used S. officinalis. The results showed that using S. officinalis gel in conjunction with SRP significantly enhanced clinical periodontal parameters. These findings indicated that S. officinalis, due to its phytochemical activities, provided a potent and secure substitute to synthetic pharmaceutical agents for the management and treatment of PD.3
Based on previous studies, the antimicrobial properties of S. officinalis are associated with the terpenes and terpenoid compounds found in this plant,24 Additionally, a study on S. officinalis identified and characterized three key multicyclic terpenoids—ferruginol, sugiol, and sclareol—which demonstrated remarkable antimicrobial properties.32 Ursolic acid and oleanolic acid, two triterpenoids of S. officinalis, have an inhibitory effect on the growth of multidrug-resistant bacteria such as penicillin-resistant Streptococcus pneumoniae,methicillin-resistant S. aureus, and vancomycin-resistant enterococci. The effect of ursolic acid on multi-drug-resistant bacteria and Enterococcus faecium is stronger than ampicillin.33 In addition, the antibacterial and antiviral effects of this extract have been attributed to compounds such as alpha,beta-thujone, and 1-8 cineol, as well as flavonoids such as apigenin. In addition, linalool, Borneol, and alpha and beta-caryophyllene compounds are also found in S. officinalis.34
In a study conducted in 2019, the anti-L. casei and anti-S. mutans properties of glass ionomer restorative cement (GIC) modified with S. officinalis extract powder were deemed safe and effective. The mean diameter of the inhibitory zones of the experimental and control groups showed a significant difference in S. mutans and L. casei, indicating the inhibitory activities of glass ionomer restorative containing S. officinalis against the selected bacteria by dose-response method.35
The results of disk diffusion in the present research showed that the ethanolic extract of walnut trunk has an inhibitory effect on L. casei and S. mutans bacteria. These values are comparable with the inhibition halo created by chlorhexidine on these two bacterial strains.
In traditional medicine, the use of various parts of the walnut tree (J. regia) to clean the teeth and oral hygiene has been considered. Nancy et al36 showed that the J. regia bark extract could be effective against cariogenic bacteria such as S. mutans, Streptococcus sobrinus, and A. viscosus. Phytochemical tests showed the presence of polyphenols, alkaloids, steroids, saponins, and tannins, and compounds rich in polyphenols and tannins in this plant prevented the growth of various microorganisms.37
Furthermore, findings from a recent study indicated that the bark of J. regia comprises juglone, which is its most significant component. Juglone has been identified as an effective agent with antibacterial, antifungal, antiplaque, anti-cariogenic, and tooth-whitening properties.38
Zakavi et al19 investigated the antimicrobial effects of aqueous and ethanolic extracts of J. regia bark on four different oral bacteria: S. aureus, Streptococcus salivarius, Streptococcus sanguis, and S. mutans. The antibacterial effect of J. regia trunk extract was evaluated in a dose-dependent manner.
A previous study indicated that the aqueous extract of J. regia leaves is effective in inhibiting the growth of gram-positive bacteria (B. subtilis, B. cereus, and S. aureus); however, gram-negative species (E. coli, K. pneumoniae, and P. aeruginosa) and fungi (C. albicans and C. neoformans) are resistant to this extract. The results indicated that the walnut tree leaves exhibited more limited antimicrobial activity than the trunk. In the J. regia plant, flavonoids showed antimicrobial properties, and quercetin and other related compounds acted mainly by inhibiting the DNA gyrase enzyme.39
Moreover, another study confirmed the therapeutic potential of J. regia extracts, attributed to the significant antimicrobial effect of its bark against Escherichia coli, Staphylococcus, Enterobacter, and Pseudomonas. These findings suggest the potential for incorporating J. regia bark into oral care practice to prevent periodontal diseases and dental caries.40
Another study also showed that J. regia bark extract significantly inhibited the growth of oral bacteria compared to standard mouthwashes such as chlorhexidine and Listerine. The inhibition zone of J. regia bark ethanolic extracts against cariogenic bacteria showed a larger inhibition zone with an average of 7.96 mm, and the distilled water extract of J. regia bark showed a lower inhibition zone with an average of 6.36 mm compared to the values reported in the present study.11
This research revealed that ethanolic extracts of J. regia bark and aerial parts of S. officinalis significantly inhibited the growth of the tested oral pathogenic microorganisms, and those reports are consistent with our findings. Despite these promising observations, this research has some limitations that require consideration. Microbial susceptibility tests only evaluate in vitro antimicrobial activities; therefore, it cannot be assured that these antimicrobial agents will be effective in clinical applications. Moreover, these tests do not provide insights into the resistance mechanisms in pathogens.
Conclusion
The results of the present study indicated that ethanolic extracts of aerial parts of S. officinalis and J. regia bark exerted extensive antibacterial effects on S. mutans and L. casei. Also, the strongest MIC and killing effect (MBC) was seen in the main bacteria known in dental caries, S. mutans by J. regia bark. The growth inhibitory effects of these extracts on C. albicans were limited, and they were only effective at high concentrations. Cytotoxicity studies showed that these extracts had no toxic effect on L929 cells at effective concentrations. Given the clinical importance of preventing caries and periodontal diseases and reducing pathogenic bacteria in the oral environment, these extracts can be used in oral and dental health products as mouthwashes, gels, and dressings in clinical practice. Supplementary in vivo studies may be needed to investigate the antimicrobial and cytotoxicity activities of synthetic nanoparticles of the extracts.
Competing Interests
The authors deny any conflicts of interest related to this study.
Consent for Publication
Not applicable.
Data Availability Statemen
All data regarding the methodology of the manuscript have been shared.
Ethical Approval
The present study was approved by the Ethics Committee of Tabriz University of Medical Sciences under the code IR.TBZMED.VCR.REC.1402.117.
Acknowledgements
The authors acknowledge the financial support provided by the Vice Chancellor for Research at Tabriz University of Medical Sciences. Also, we would like to thank Dr. Roya Bodaghlu, Dr. Ali Akbar Alizade and Atabak Naiyeri for their cooperation in this research.
References
- Bernabe E, Marcenes W, Hernandez CR, Bailey J, Abreu LG, Alipour V. Global, regional, and national levels and trends in burden of oral conditions from 1990 to 2017: a systematic analysis for the global burden of disease 2017 study. J Dent Res 2020; 99(4):362-73. doi: 10.1177/0022034520908533 [Crossref] [ Google Scholar]
- Hajishengallis G. Periodontitis: from microbial immune subversion to systemic inflammation. Nat Rev Immunol 2015; 15(1):30-44. doi: 10.1038/nri3785 [Crossref] [ Google Scholar]
- Aljuboori IW, Mahmood MS, Al-Rihaymee SA. Clinical effectiveness of Salvia officinalis in periodontitis: a split-mouth randomized controlled trial. Cureus 2024; 16(4):e58582. doi: 10.7759/cureus.58582 [Crossref] [ Google Scholar]
- Kidd E. The implications of the new paradigm of dental caries. J Dent 2011; 39 Suppl 2:S3-8. doi: 10.1016/j.jdent.2011.11.004 [Crossref] [ Google Scholar]
- Mathur VP, Dhillon JK. Dental caries: a disease which needs attention. Indian J Pediatr 2018; 85(3):202-6. doi: 10.1007/s12098-017-2381-6 [Crossref] [ Google Scholar]
- Fine DH, Goldberg D, Karol R. Caries levels in patients with juvenile periodontitis. J Periodontol 1984; 55(4):242-6. doi: 10.1902/jop.1984.55.4.242 [Crossref] [ Google Scholar]
- Sewón LA, Parvinen TH, Sinisalo TV, Larmas MA, Alanen PJ. Dental status of adults with and without periodontitis. J Periodontol 1988; 59(9):595-8. doi: 10.1902/jop.1988.59.9.595 [Crossref] [ Google Scholar]
- Li Y, Xiang Y, Ren H, Zhang C, Hu Z, Leng W. Association between periodontitis and dental caries: a systematic review and meta-analysis. Clin Oral Investig 2024; 28(6):306. doi: 10.1007/s00784-024-05687-2 [Crossref] [ Google Scholar]
- Abbood HM, Hijazi K, Gould IM. Chlorhexidine resistance or cross-resistance, that is the question. Antibiotics (Basel) 2023; 12(5):798. doi: 10.3390/antibiotics12050798 [Crossref] [ Google Scholar]
- Brookes ZLS, Bescos R, Belfield LA, Ali K, Roberts A. Current uses of chlorhexidine for management of oral disease: a narrative review. J Dent 2020; 103:103497. doi: 10.1016/j.jdent.2020.103497 [Crossref] [ Google Scholar]
- Ibrahim Ibrahim, Bhardwaj N, Puri A, Wadhwan V, Nangia R, Jahan I. Antimicrobial effect of Juglans regia bark with commonly used antibiotics against initial colonizers of plaque and caries: a comparative study. J Oral Maxillofac Pathol 2023; 27(3):443-54. doi: 10.4103/jomfp.jomfp_187_23 [Crossref] [ Google Scholar]
- Javed A, Venkatesha RT, Sagar S, Parameswaraiah MV, Ganguly D, Murugan S. In vitro evaluation of the synergistic antimicrobial effect of Boswellia sacra and Nigella sativa, essential oil on human pathogenic microbial strains. Am J Phytomed Clin Ther 2015; 3:185-92. [ Google Scholar]
- El-Tarabily KA, El-Saadony MT, Alagawany M, Arif M, Batiha GE, Khafaga AF. Using essential oils to overcome bacterial biofilm formation and their antimicrobial resistance. Saudi J Biol Sci 2021; 28(9):5145-56. doi: 10.1016/j.sjbs.2021.05.033 [Crossref] [ Google Scholar]
- Kale AA, Gadkari TV, Devare SM, Deshpande NR, Salvekar JP. GC-MS study of stem bark extract of Juglans regia L. Res J Pharm Biol Chem Sci 2012; 3(1):740-3. [ Google Scholar]
- Wichtl M, Anton R. Plantes Thérapeutiques-Technique et Documentation. Paris; 1999.
- Cosmulescu S, Trandafir I, Nour V. Seasonal variation of the main individual phenolics and juglone in walnut (Juglans regia) leaves. Pharm Biol 2014; 52(5):575-80. doi: 10.3109/13880209.2013.853813 [Crossref] [ Google Scholar]
- Hosseinzadeh H, Zarei H, Taghiabadi E. Antinociceptive, anti-inflammatory and acute toxicity effects of Juglans regia L. leaves in mice. Iran Red Crescent Med J 2011; 13(1):27-33. [ Google Scholar]
- Santos A, Barros L, Calhelha RC, Dueñas M, Carvalho AM, Santos-Buelga C. Leaves and decoction of Juglans regia L.: different performances regarding bioactive compounds and in vitro antioxidant and antitumor effects. Ind Crops Prod 2013; 51:430-6. doi: 10.1016/j.indcrop.2013.10.003 [Crossref] [ Google Scholar]
- Zakavi F, Golpasand Hagh L, Daraeighadikolaei A, Farajzadeh Sheikh A, Daraeighadikolaei A, Leilavi Shooshtari Z. Antibacterial effect of Juglans regia bark against oral pathologic bacteria. Int J Dent 2013; 2013:854765. doi: 10.1155/2013/854765 [Crossref] [ Google Scholar]
- Wichtl M. Herbal Drugs and Phytopharmaceuticals: A Handbook for Practice on a Scientific Basis. CRC Press; 2004.
- Miura K, Kikuzaki H, Nakatani N. Apianane terpenoids from Salvia officinalis. Phytochemistry 2001; 58(8):1171-5. doi: 10.1016/s0031-9422(01)00341-7 [Crossref] [ Google Scholar]
- Ray AB, Sarma BK, Singh UP. Medicinal Properties of Plants: Antifungal, Antibacterial, and Antiviral Activities. IBDC Publishers; 2004.
- Hayouni EA, Chraief I, Abedrabba M, Bouix M, Leveau JY, Mohammed H. Tunisian Salvia officinalis L. and Schinus molle L. essential oils: their chemical compositions and their preservative effects against Salmonella inoculated in minced beef meat. Int J Food Microbiol 2008; 125(3):242-51. doi: 10.1016/j.ijfoodmicro.2008.04.005 [Crossref] [ Google Scholar]
- Longaray Delamare AP, Moschen-Pistorello IT, Artico L, Atti-Serafini L, Echeverrigaray S. Antibacterial activity of the essential oils of Salvia officinalis L. and Salvia triloba L. cultivated in South Brazil. Food Chem 2007; 100(2):603-8. doi: 10.1016/j.foodchem.2005.09.078 [Crossref] [ Google Scholar]
- Salem Y, El-Mossalami H, Mousa M. Microbiological criteria of local manufactured beef luncheon. Alex J Vet Sci 2016; 51(2):381-5. doi: 10.5455/ajvs.223118 [Crossref] [ Google Scholar]
- Karou D, Dicko MH, Simpore J, Traore AS. Antioxidant and antibacterial activities of polyphenols from ethnomedicinal plants of Burkina Faso. Afr J Biotechnol 2005; 4(8):823-8. [ Google Scholar]
- Noumi E, Snoussi M, Trabelsi N, Hajlaoui H, Ksouri R, Valentin E. Antibacterial, anticandidal and antioxidant activities of Salvadora persica and Juglans regia L. J Med Plants Res 2011; 5(17):4138-46. [ Google Scholar]
- Mac Faddin JF. Biochemical Tests for Identification of Medical Bacteria. Lippincott Williams & Wilkins; 1980.
- Wiegand I, Hilpert K, Hancock RE. Agar and broth dilution methods to determine the minimal inhibitory concentration (MIC) of antimicrobial substances. Nat Protoc 2008; 3(2):163-75. doi: 10.1038/nprot.2007.521 [Crossref] [ Google Scholar]
- Kermanshah H, Hashemi Kamangar SS, Arami S, Kamalinegad M, Karimi M, Mirsalehian A. The effect of hydro alcoholic extract of seven plants on cariogenic bacteria--an in vitro evaluation. Oral Health Dent Manag 2014; 13(2):395-401. [ Google Scholar]
- Sookto T, Srithavaj T, Thaweboon S, Thaweboon B, Shrestha B. In vitro effects of Salvia officinalis L. essential oil on Candida albicans. Asian Pac J Trop Biomed 2013; 3(5):376-80. doi: 10.1016/s2221-1691(13)60080-5 [Crossref] [ Google Scholar]
- Purgato GA, Píccolo MS, Moreira MAS, Pizziolo VR, Diaz-Muñoz G, Rossi CC. Isolation and identification of antimicrobial multicyclic terpenoids from the medicinal plant Salvia officinalis and development of a formulation against clinical Staphylococcus aureus strains. Lett Appl Microbiol 2024; 77(8):ovae077. doi: 10.1093/lambio/ovae077 [Crossref] [ Google Scholar]
- Horiuchi K, Shiota S, Hatano T, Yoshida T, Kuroda T, Tsuchiya T. Antimicrobial activity of oleanolic acid from Salvia officinalis and related compounds on vancomycin-resistant enterococci (VRE). Biol Pharm Bull 2007; 30(6):1147-9. doi: 10.1248/bpb.30.1147 [Crossref] [ Google Scholar]
- Walker JB. Evaluation of the ability of seven herbal resources to answer questions about herbal products asked in drug information centers. Pharmacotherapy 2002; 22(12):1611-5. doi: 10.1592/phco.22.17.1611.34126 [Crossref] [ Google Scholar]
- Shahriari S, Barekatain M, Shahtalebi MA, Farhad SZ. Evaluation of preventive antibacterial properties of a glass-ionomer cement containing purified powder of Salvia officinalis: an in vitro study. Int J Prev Med 2019; 10:110. doi: 10.4103/ijpvm.IJPVM_81_17 [Crossref] [ Google Scholar]
- Nancy P, Manasi M, Varghese A. Antiplaque activity of Juglans regia L. and characterization of juglone from Juglans regia L. Am J Biochem Biotechnol 2011; 7(1):29-31. [ Google Scholar]
- Güngör ÖE, Kırzıoğlu Z, Dinçer E, Kıvanç M. Who will win the race in childrens’ oral cavities? Streptococcus mutans or beneficial lactic acid bacteria?. Benef Microbes 2013; 4(3):237-45. doi: 10.3920/bm2012.0055 [Crossref] [ Google Scholar]
- Khattak P, Khalil TF, Bibi S, Jabeen H, Muhammad N, Khan MA. Juglans regia (walnut tree) bark in dentistry: walnut tree bark in dentistry. Pak Biomed J 2022; 5(2):152-6. doi: 10.54393/pbmj.v5i2.201 [Crossref] [ Google Scholar]
- Pereira JA, Oliveira I, Sousa A, Valentão P, Andrade PB, Ferreira IC. Walnut (Juglans regia L.) leaves: phenolic compounds, antibacterial activity and antioxidant potential of different cultivars. Food Chem Toxicol 2007; 45(11):2287-95. doi: 10.1016/j.fct.2007.06.004 [Crossref] [ Google Scholar]
- Al-Rawi R, Bashir Y, Mustafa A, Omar M, Al-Rawi N, Saeed M. Teeth whitening and antibacterial effects of Juglans regia bark: a preliminary study. Int J Dent 2021; 2021:6685437. doi: 10.1155/2021/6685437 [Crossref] [ Google Scholar]